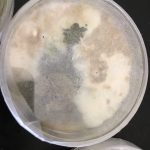
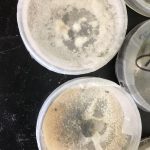

It’s been three weeks since we last met with the second year B.A.M. students at Forest Heights Academy. During our last session, the students plated their potentially diseased red mangrove leaves in agar. Since Ryann Rossi and I returned to the United States, the students have been making observations and recording them in their mangrove journals. They recorded whether there was bacterial contamination and/or fungus present after 3 days, 1 week, 2 weeks, and 3 weeks. If fungus was present, the students identified the opacity, color, and described the colonies.
Proud students at Forest Heights Academy hold up their “plated” mangrove leaves
Potentially diseased leaves plated in agar medium
Today was the big reveal – would the students find the same fungi that Ryann has been finding in her study? Ryann and I joined the Skype call to discuss the order of events for our session with the students. I was anxious to find out the students’ results and it as apparent from our conversation that Ryann was too. In great anticipation, we Skyped the students at Forest Heights Academy.
FRIENDS Outreach Coordinator, Cassandra Abraham and James Richard, Principal at Forest Heights Academy take a selfie with our Director of Education, Amy Heemsoth and Ryann Rossi, PhD candidate at North Carolina State University who are on a video conference call with Mr. Richard’s class.
First, Ryann showed the students pictures of the most common fungi that she has found. She explained how to differentiate between bacterial contamination and fungi and discussed how to identify each fungus by various characteristics. After providing this background knowledge, the students retrieved their agar plates and began observing their growth and if present, classified the fungus to genus. Ryann and I remained on the video call so that students could confirm with Ryann if they had identified their fungus correctly.
Forest Heights student discusses the fungi on his agar plate with Ryann who is on a video call with the class.
As the students approached the computer one-by-one, we quickly started to comprehend that the students had in fact cultured not just one of the fungi that Ryann was finding in her samples, but all the different types of fungi. I could tell by Ryann’s voice that she was excited. The students had even cultured the prime mangrove disease suspect – Pestalotiopsis. This genus of fungi is the one that Ryann believes to be partially responsible for the mangrove die-off in the Bahamas.

“Pestalotiopsis” student plate results – growth after 3 weeks
In addition to identifying their fungi species, the students also placed their plates under a microscope to take a closer look at them. In their mangrove journals, the students drew the fungus and tried to identify the different fungal characteristics such as hyphae, mycelium, and spores.



B.A.M. students at Forest Heights Academy classify their fungus and investigate the structures present.
You may be wondering what will happen to the data that the B.A.M. students collected. The students’ data will be provided to Ryann and she will add this information to her larger database that contains information from the citizen science work that she previously conducted in Abaco, Bahamas. I’m glad that we could partner with North Carolina State University to include a section on mangrove disease in our curriculum. The students learned new scientific techniques while contributing to ongoing science in the Bahamas. It was a nice addition and added a lot of value to our year 2 B.A.M. program. Thanks Ryann for your expertise!






